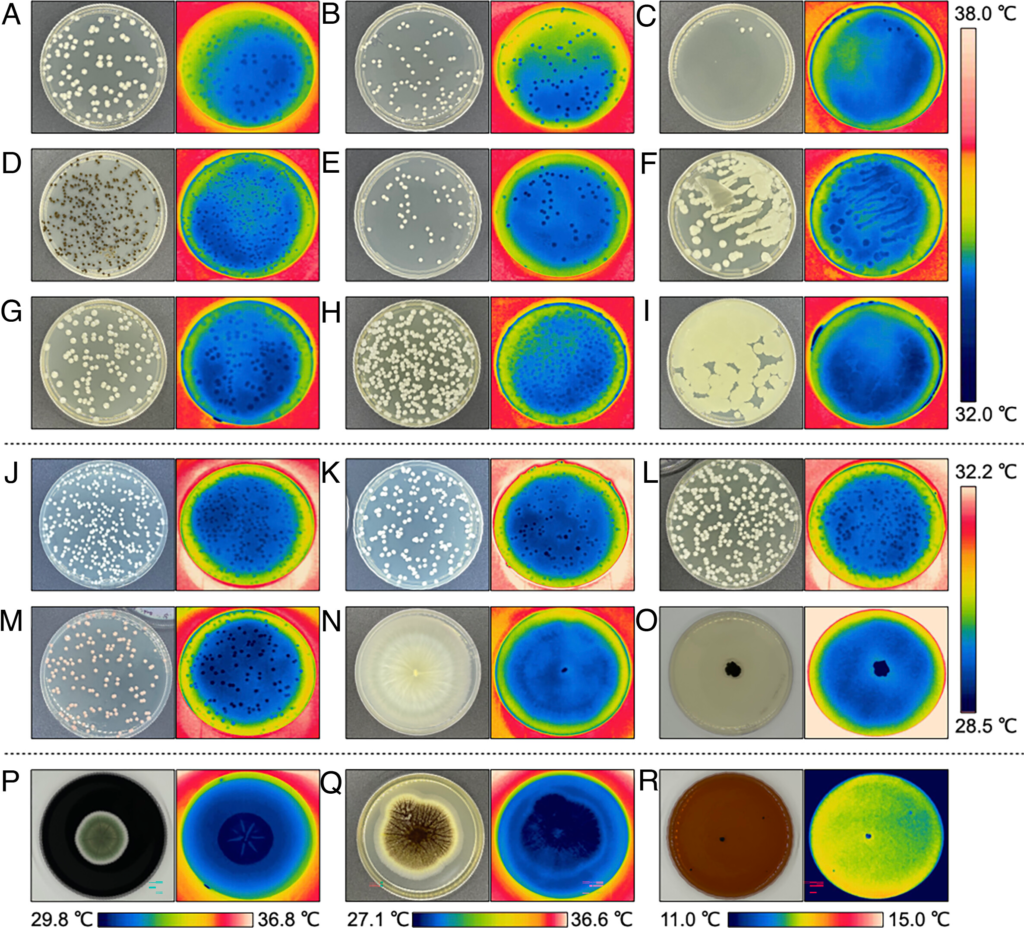

Температура є одним з найбільш важливих чинників довкілля. Низька температура призводить до замерзання води – середовища внутрішньоклітинних біохімічних реакцій. Надмірно висока – до денатурації білків та втрати ними функціональності. А між цими крайніми точками вона впливає на перебіг хімічних реакцій – що вища температура, то швидше вони відбуваються.
Зважаючи на таку важливість цього параметра, організми навчилися ним певною мірою керувати. Певно, найефективніше це роблять тварини. Деякі – ссавці та птахи – виробили біохімічні шляхи постійного підтримання порівняно високої внутрішньої температури, що дозволяє їм бути стабільно активними навіть за низької температури довкілля. Такі організми називаються гомойотермними (чи простіше “теплокровними”). До них належимо і ми.
Рослини також певною мірою здатні керувати температурою. Випаровуючи воду з поверхні листків, вони охолоджуються, а за рахунок енерговитратних хімічних реакцій можуть дещо нагрівати якісь частини – наприклад, квітки. Це допомагає випаровувати ароматичні сполуки, які, які власне тепло, приваблюють комах запилювачів.
Щодо здатності до терморегуляції іншої групи еукаріотичних організмів – грибів – досі було мало відомо. Температура принаймні деяких з них зазвичай менша за таку довкілля. Проте, чи це притаманне усім грибам – було питанням.
Учені провели детальне дослідження із використанням інфрачервоної термографії. Вони виявили, що гіпотермія притаманна не лише “великим” плодовим тілам шапинкових грибів, а й примітивнішим за будовою дріжджам чи пліснявим грибам. Аналіз представників 20 видів дикорослих грибів показав, що їхня температура була нижчою за довкілля на 1.4-5.9 °C. Те ж було притаманним і колоніям культивованих на агар-агарі мікроскопічних грибів. Деякі з них підтримували нижчу за середовище температуру навіть, коли вирощувалися при 4 °C. Плодові тіла виявилися холоднішими за решту міцелію.
Деякі види грибів пристосовані до існування за досить низьких температур – наприклад, дріжджі Naganishia antarctica зберігають активність при +4 °C. Здавалося б, куди ж холодніше? Але і вони виявилися більш холодними за довкілля.
Здатність знижувати власну температуру збільшувалася по мірі росту колоній. Ключовим механізмом самоохолодження є випаровування рідини. У дегітратованих грибів ця здатність порушувалася.
Автори вирішили використати охолоджувальну здатність грибів з практичною метою і створили прототип системи пасивного охолодження повітря на основі печериць (Agaricus bisporus). Їх помістили у пінопластовий бокс, через який за допомогою вентилятора проганялося повітря.

Прилад назвали MycoCooler™. За 40 хвилин його роботи температура всередині боксу знизилася з 38 до 28 °C. Просочена водою губка еквівалентної маси за такий же час знизила температуру на 7.7 °C, тож охолоджувальна здатність грибів є вищою за пасивне випаровування води. Крім охолодження, такий пристрій можна використовувати і для зволоження повітря. Звісно, поки що це лише демонстрація принципу, але ідея екологічно чистого кондиціонеру, який ще й дає врожай, є цікавою.
Біологічне значення грибної гіпотермії поки не зовсім зрозуміле. Припускається, що холодніша за оточення поверхня ефективніше забезпечує від’єднання та вивільнення спор. Не виключено, що нижча температура потрібна для процесу утворення спор. Подібне ми знаємо у ссавців – процес сперматогенезу вимагає температури, нижчої за таку у черевній порожнині, через що чоловічі статеві залози винесені для охолодження у спеціальний компартмент, мошонку. А, наприклад, у дріжджів інтенсивність спороношення є помітно вищою при 22 °C порівняно із 30 °C. Також можливо, що нижча температура приваблює деяких комах, які допомагають поширювати спори.
Оскільки гриби становлять приблизно 2% біомаси Землі, їхнє випаровування може сприяти більш прохолодним температурам у певних екосистемах, але це ще потрібно з’ясувати.
Отже, схоже, що гіпотермність грибів є їхньою ключовою особливістю. Вивчення молекулярних механізмів підтримання нижчої за довкілля температури може в майбутньому призвести до цілої низки різноманітних новацій у біотехнологіях, медицині чи відновлювальної енергетики.
Джерело: Cordero RJB, Mattoon ER, Ramos Z, Casadevall A. The hypothermic nature of fungi. Proc Natl Acad Sci U S A. 2023 May 9;120(19):e2221996120. doi: 10.1073/pnas.2221996120

Залишити відповідь